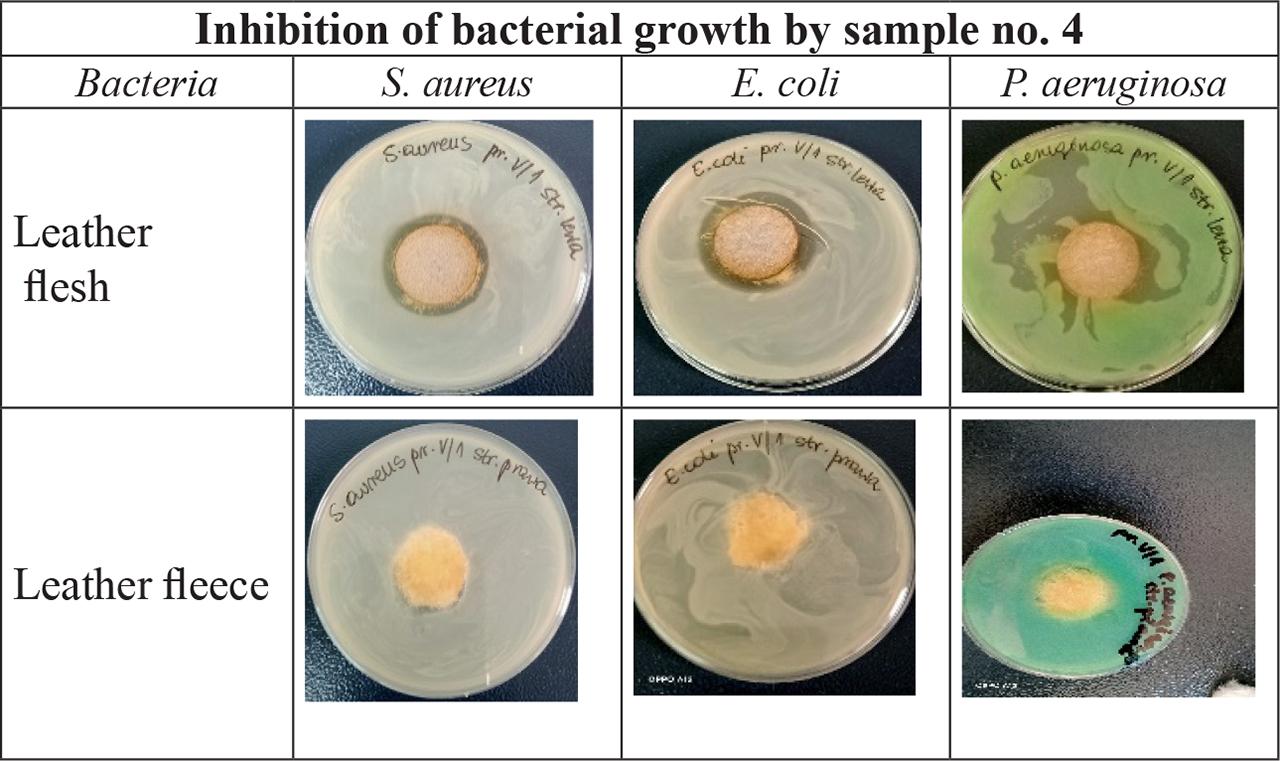
Inhibition demonstration of bacterial growth by sample no. 4
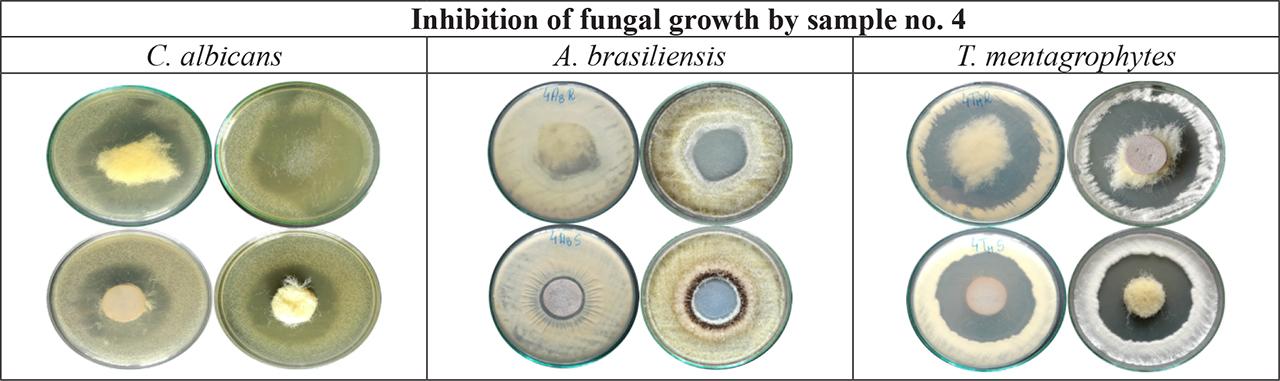
Inhibition demonstration of fungal growth by sample no. 4

Fig. 1.

Fig. 2.

Fig. 3.

Fig. 4.
Fig. 5.
Determination of the antibacterial activity of leather samples against bacteria: S_ aureus, E_ coli and P_ aeruginosa
| Sample No. | Staphylococcus aureus | Escherichia coli | Pseudomonas aeruginosa | ||||||
|---|---|---|---|---|---|---|---|---|---|
| Inhibition zone of growth [mm] W/S | Growth W/S | Assessment W/S | Inhibition zone of growth [mm] W/S | Growth W/S | Assessment W/S | Inhibition zone of growth [mm] W/S | Growth W/S | Assessment W/S | |
| 1 | 0/0 | heavy/none | insufficient effect/good effect | 0/0 | heavy/none | insufficient effect/good effect | 0/0 | heavy/none | insufficient effect/good effect |
| 2 | 0/0 | heavy/none | insufficient effect/good effect | 0/0 | heavy/none | insufficient effect/good effect | 0/0 | heavy/none | insufficient effect/good effect |
| 3 | 0/6 | heavy/none | insufficient effect/good effect | 0/7 | heavy/none | insufficient effect/good effect | 0/7,5 | heavy/none | insufficient effect/good effect |
| 4 | 1,5/5,5 | none/none | good effect/good effect | 1,5/7 | none/none | good effect/good effect | 0/2,5 | none/none | good effect/good effect |
Determination of antifungal activity of leather samples against fungi: C_ albicans, A_ brasiliensis and T_ mentagrophytes
| Sample number | Candida albicans | Aspergillus brasiliensis | Trichophyton mentagrophytes | ||||||
|---|---|---|---|---|---|---|---|---|---|
| Inhibition zone of growth [mm] W/S | Assessment of growth on samples W/S | Assessment of growth in agar medium under the samples W/S | Inhibition zone of growth [mm] W/S | Assessment of growth on samples W/S | Assessment of growth in agar medium under the samples W/S | Inhibition zone of growth [mm] W/S | Assessment of growth on samples W/S | Assessment of growth in agar medium under the samples W/S | |
| 1 | 0/0 | 1*/1 | 5/5 | 0/0 | 4/3 | 5/3 | 0/0 | 3/3 | 4/2 |
| 2 | 0/0 | 1*/1 | 5/4 | 0/0 | 4/2 | 4/3 | 0/0 | 3/2 | 4/1 |
| 3 | 0/0 | 1*/0 | 5/0 | 0/53 | 3/0 | 4/0 | 0/62 | 3/0 | 4/0 |
| 4 | 54/65 | 0/0 | 0/0 | 0/29 | 0/0 | 0/0 | 71/59 | 0/0 | 0/0 |
Test results of physical and chemical parameters for sheep skins protected with an agent containing a zinc pyrithione formulation_
| No. | Indicator name | Unit of measure | Result | Technical requirements according to ŁIT in Krakow | Method |
|---|---|---|---|---|---|
| 1. |
| N |
| ≥ 100 | PN –EN ISO 3376:2012 |
| 2. |
| % |
| ≥ 50 | |
| 3. |
| ºC |
| > 70 | PN-EN ISO 3380:2015-11 |
| 4. |
| number of cycles |
|
| PN-EN ISO 20344:2012 p.6.12 |
| 5. |
| - |
|
| PN-EN ISO 4045:2018-09 |
| 6. | Water vapour permeability | mg/(cm2 h) | 11,43 | ≥ 4 |
|
| Water vapour absorption | mg/cm2 | 7,74 | not normalized | ||
| 7. | Water vapour coefficient | mg/cm2 | 99,2 | min. 33 | |
| 8. |
| N |
| ≥ 70 | PN-EN ISO 23910 |
| 9. | Formaldehyde | mg/kg | (58,1 ±0,8) | ≤ 75,0 | PN-EN ISO 17226-2:2019-05 |
| 10. | Chrome(VI) | mg/kg | undetectable 1/ | undetectable | PN-EN ISO 5398-2:2010 |